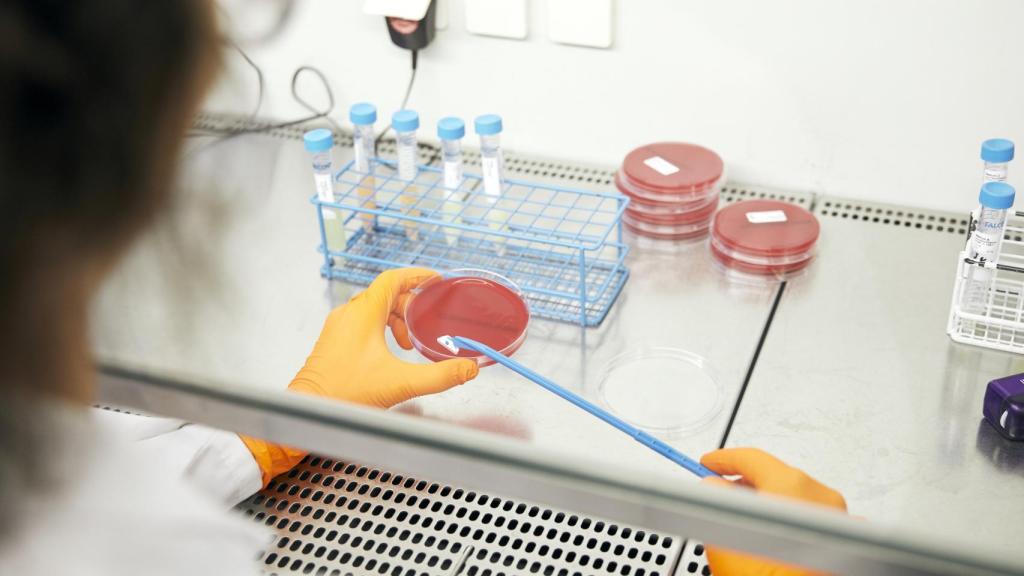
Cáncer: el ‘mordisco’ definitivo de la inmunoterapia que dota a las defensas de 'superpoderes'

Cáncer: el ‘mordisco’ definitivo de la inmunoterapia que dota a las defensas de 'superpoderes'
Cáncer: el 'mordisco' definitivo de la inmunoterapia que dota a las defensas de 'superpoderes'
La plataforma Bite consigue que determinados compuestos logren aumentar la capacidad anticáncer de las células T.
Noticias relacionadas
El cáncer es la segunda causa de muerte en todo el mundo, según la Organización Mundial de la Salud (OMS). Fallecen tantas personas a causa de este nombre común que recoge un conjunto de enfermedades -más de 113.000 en España-, que los científicos no paran de investigar cómo luchar contra él. A pesar de los recientes avances en inmunoterapia, no hay suficientes pacientes que se beneficien de los tratamientos actuales.
Parece claro que se necesita avanzar más en el conocimiento de esta técnica -que consigue que sean las propias defensas del organismo las que acaben con las células que crecen descontroladas en un proceso tumoral- para tratar tanto las neoplasias malignas hematológicas (leucemias y linfomas) como los tumores sólidos.
Diversos laboratorios de universidades y empresas farmacéuticas y biotecnológicas se centran en descubrir cómo mejorar esos mecanismos y hacer de la inmunoterapia un tratamiento accesible para un mayor número de pacientes. EL ESPAÑOL ha viajado a uno de ellos, en el centro de investigación de la compañía Amgen en Múnich, para conocer de primera mano una nueva tecnología que está en fase de desarrollo: un mordisco definitivo de la inmunoterapia que dotará a las defensas de superpoderes.
En los laboratorios alemanes están trabajando en una innovadora plataforma tecnológica llamada Bite (Bispecific T Cell Engager) -cuyas siglas traducidas del inglés significan mordisco- con 12 moléculas distintas para tratar varios tipos de cáncer. En concreto, están centrados en el mieloma múltiple, la leucemia, el cáncer de próstata, el de pulmón de células no pequeñas y el glioblastoma -un tipo de tumor cerebral-.
Bite inmunoterapia
"Unas gafas" contra las células cancerosas
La inmunoterapia que están desarrollando en la compañía tiene como protagonistas a las células T de los pacientes con antígenos tumorales. Estas desempeñan un papel importante en el sistema inmunológico -las defensas- del cuerpo al identificar y eliminar las células cancerosas. Sin embargo, las cancerosas pueden desarrollar mecanismos para evadir el reconocimiento y evitar ser destruidas.
La tecnología Bite está diseñada para superar esta evasión de las células cancerosas del sistema inmunológico animando a las células T de los pacientes a atacar directamente a los tumores.

Laboratorio de Amgen en Múnich
En concreto, las 12 moléculas sobre las que trabaja Amgen están diseñada para activar el potencial citotóxico (cualidad de las células para ser tóxicas frente a otras que están alteradas) de las células T con el objetivo de eliminar las cancerosas.
"Las moléculas Bite son como unas gafas para nuestras células T. Permiten que estas vean a las células cancerosas como un enemigo natural y las ataquen", explica Peter Kufer, profesor de Inmunología de la Universidad de Múnich. "Matar la semilla antes de que crezca, ese es nuestro objetivo", añade el investigador, que también es inventor de esta terapia.
Además, una vez que las células T son activadas por alguna de las 12 moléculas de Bite, ellas mismas pueden inducir una mayor proliferación de células T. Esto se traduce en que después de la muerte de las células cancerosas, las células T activadas liberan citoquinas (agentes responsables de la comunicación intercelular) y producen moléculas encargadas de la immunoregulación del sistema inmunitario que pueden permitir que las células T se dirijan a las células cancerosas circundantes.

Laboratorio de Amgen en Múnich
Bite ha sido estudiado en miles de pacientes y algunos de los casos se han seguido durante cinco años. Ahora mismo, la plataforma inmunooncológica continúa siendo investigada en múltiples tumores malignos hematológicos diferentes y tumores sólidos.
Por otro lado, aunque lo que más reluce son las 12 moléculas que luchan contra los cinco tipos de cáncer, la empresa está desarrollando decenas más. Isma Benattia, vicepresidenta médica de Amgen para Europa, lo explica así: "Tenemos más de 50 moléculas en desarrollo, 12 de ellas dirigidas a la investigación en oncología, pero también hay numerosos proyectos en las áreas de enfermedades cardiovasculares, neurociencia, inflamación y salud ósea".



